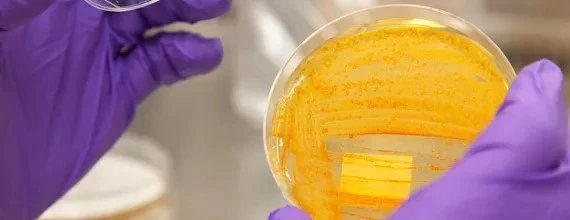
Антимікробна резистентність (AMR)

Програми охорони здоров’я
Ми інтегруємо комплексний підхід до лікування чотирьох захворювань з обмеженим фінансуванням на дослідження та розробки. Ми прагнемо усунути чи посилити контроль над захворюваннями, фокусуючись на провідних програмах: лікування малярії, серповидної анемії, хвороби Шагаса та прокази. Ми використовуємо координований підхід до інших нагальних проблем, таких як незрячість, що піддається профілактиці, резистентність до антибіотиків.